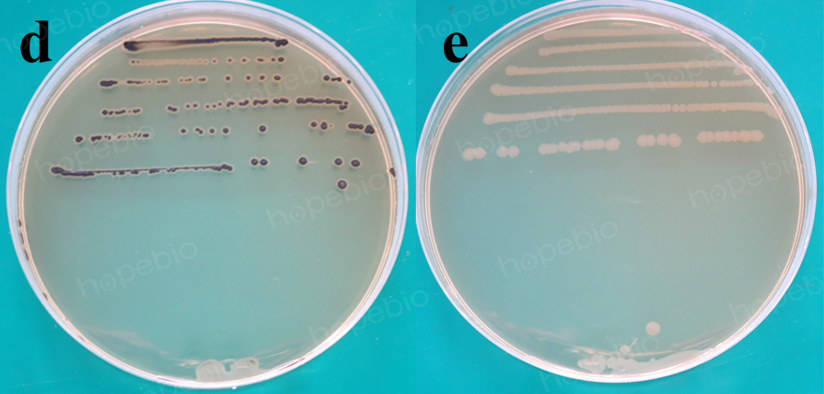

海博微信公众号
海博天猫旗舰店




阪崎肠杆菌显色培养基是青岛海博生物公司根据GB4789.40生产的培养基,胰蛋白胨、大豆蛋白胨提供营养,氯化钠维持渗透压,琼脂为凝固剂,脱氧胆酸钠主要抑制革兰氏阳性菌的生长,柠檬酸铁铵、硫代硫酸钠可使产硫化氢的非目标菌呈黑色中心,阪崎肠杆菌可特异性分解底物5-溴-4-氯-3-吲哚-α-D-吡喃葡糖甙使菌落显蓝—绿色,其它不产硫化氢、不分解底物的菌一般显无色或黄色。
二、培养基配方(g/L):
|
胰蛋白胨 |
15.0 |
|
大豆蛋白胨 |
5.0 |
|
氯化钠 |
5.0 |
|
柠檬酸铁铵 |
1.0 |
|
硫代硫酸钠 |
1.0 |
|
脱氧胆酸钠 |
1.0 |
|
5-溴-4-氯-3-吲哚-α-D-吡喃葡糖甙 |
0.1 |
|
琼脂 |
15.0 |
|
pH 7.3±0.2 25℃ |
|
接种以下质控菌株,放置36±1℃需氧培养18-24小时。
|
质控菌株 |
菌株编号 |
接种量 (CFU) |
参比或计 数培养基 |
方法 |
质控评 定标准 |
其他特征 |
|
阪崎肠杆菌 |
ATCC29004 |
20-200 |
TSA |
定量 |
PR≥0.5 |
蓝绿色菌落 |
|
金黄色葡萄球菌 |
ATCC25923 |
/ |
/ |
半定量 |
G≤1 |
/ |
|
大肠埃希氏菌 |
ATCC25922 |
/ |
|
|
/ |
黄色菌落 |
|
伤寒沙门氏菌 |
ATCC14028 |
/ |
/ |
定性 |
/ |
无色菌落,有黑色中心 |
|
肺炎克雷伯氏菌 |
ATCC10031 |
/ |
|
|
/ |
无色菌落 |

图1-2 阪崎肠杆菌显色培养基(DFI琼脂)微生物质控结果
本培养基仅为细菌鉴定的一部分,需做其他补充试验。
相关产品:
阪崎肠杆菌显色培养基(DFI琼脂)(200g)-点击查看产品详情
阪崎肠杆菌显色培养基(DFI琼脂)(1000ml)-点击查看产品详情
注:本文属海博生物原创,未经允许不得转载。
上一篇:尿素酶生化管原理及实验现象
下一篇:葡萄糖酸盐试验原理与方法
